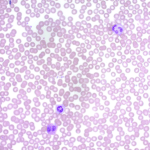
Jenner Stain Solution

Jenner Stain Solution
Voici le seul résultat
-
Jenner Stain Solution
The Jenner Stain Solution is a mixture of several thiazin-dyes in a methanol solvent. Ionic and nonionic forces are involved in the binding of these dyes.RT Unit : 500 mlRef: D26033-05